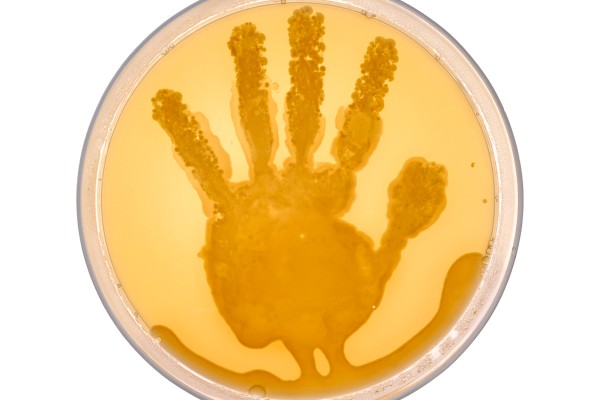

© Edgar Lissel, Myself
Vortrag
Die Schwelle des Sichtbaren Die Schwelle des Sichtbaren
Ein Ausloten der fotografischen Parameter – Edgar Lissel stellt seine Arbeiten vor
Edgar Lissel Künstler, Wien
Edgar Lissel (*1965 in Northeim, DE) studierte Fotografie an der Hochschule Darmstadt.
In seinen interdisziplinären Projekten spürt er den Spannungen zwischen Naturwissenschaft, Kunstgeschichte, Archäologie und künstlerischer Intention nach und untersucht Bildprozesse und den ephemeren Zustand des Bildes. In seiner aktuellen Arbeit „Passagen“ beschäftigt Edgar Lissel sich mit dem Gegensatz von Logos und Mythos und begibt sich auf die Suche nach dem Bildverständnis antiker Mythen und ihrer tiefenpsychologischen Bedeutung bis die heutige Zeit.
Arbeiten von Edgar Lissel sind in nationalen und internationalen Ausstellungen präsentiert worden und in folgenden Sammlungen vertreten (Auswahl): National Gallery of Canada, Sammlung der Bundesrepublik Deutschland, Victoria & Albert Museum (London), Museum der Moderne (Salzburg), MUSA - Sammlung zeitgenössischer Kunst der Stadt Wien. Im Jahr 2007 wurde Lissel von der Deutschen Gesellschaft für Fotografie mit dem renommierten Herbert-Schober-
Preis ausgezeichnet.
Seit 1998 unterrichtet Edgar Lissel Kunst und Fotografie an verschiedenen Universitäten und Hochschulen in Österreich (2005-2009 Universität für angewandte Kunst Wien) und Deutschland, zuletzt 2010 als Gastprofessor an der Folkwang Universität der Künste in Essen. Seit 2005 lebt er in Wien.
http://www.edgarlissel.de
In seinen interdisziplinären Projekten spürt er den Spannungen zwischen Naturwissenschaft, Kunstgeschichte, Archäologie und künstlerischer Intention nach und untersucht Bildprozesse und den ephemeren Zustand des Bildes. In seiner aktuellen Arbeit „Passagen“ beschäftigt Edgar Lissel sich mit dem Gegensatz von Logos und Mythos und begibt sich auf die Suche nach dem Bildverständnis antiker Mythen und ihrer tiefenpsychologischen Bedeutung bis die heutige Zeit.
Arbeiten von Edgar Lissel sind in nationalen und internationalen Ausstellungen präsentiert worden und in folgenden Sammlungen vertreten (Auswahl): National Gallery of Canada, Sammlung der Bundesrepublik Deutschland, Victoria & Albert Museum (London), Museum der Moderne (Salzburg), MUSA - Sammlung zeitgenössischer Kunst der Stadt Wien. Im Jahr 2007 wurde Lissel von der Deutschen Gesellschaft für Fotografie mit dem renommierten Herbert-Schober-
Preis ausgezeichnet.
Seit 1998 unterrichtet Edgar Lissel Kunst und Fotografie an verschiedenen Universitäten und Hochschulen in Österreich (2005-2009 Universität für angewandte Kunst Wien) und Deutschland, zuletzt 2010 als Gastprofessor an der Folkwang Universität der Künste in Essen. Seit 2005 lebt er in Wien.
http://www.edgarlissel.de
20. Mar 2012
10 Uhr
10 Uhr
Rustenschacherallee 2-4
